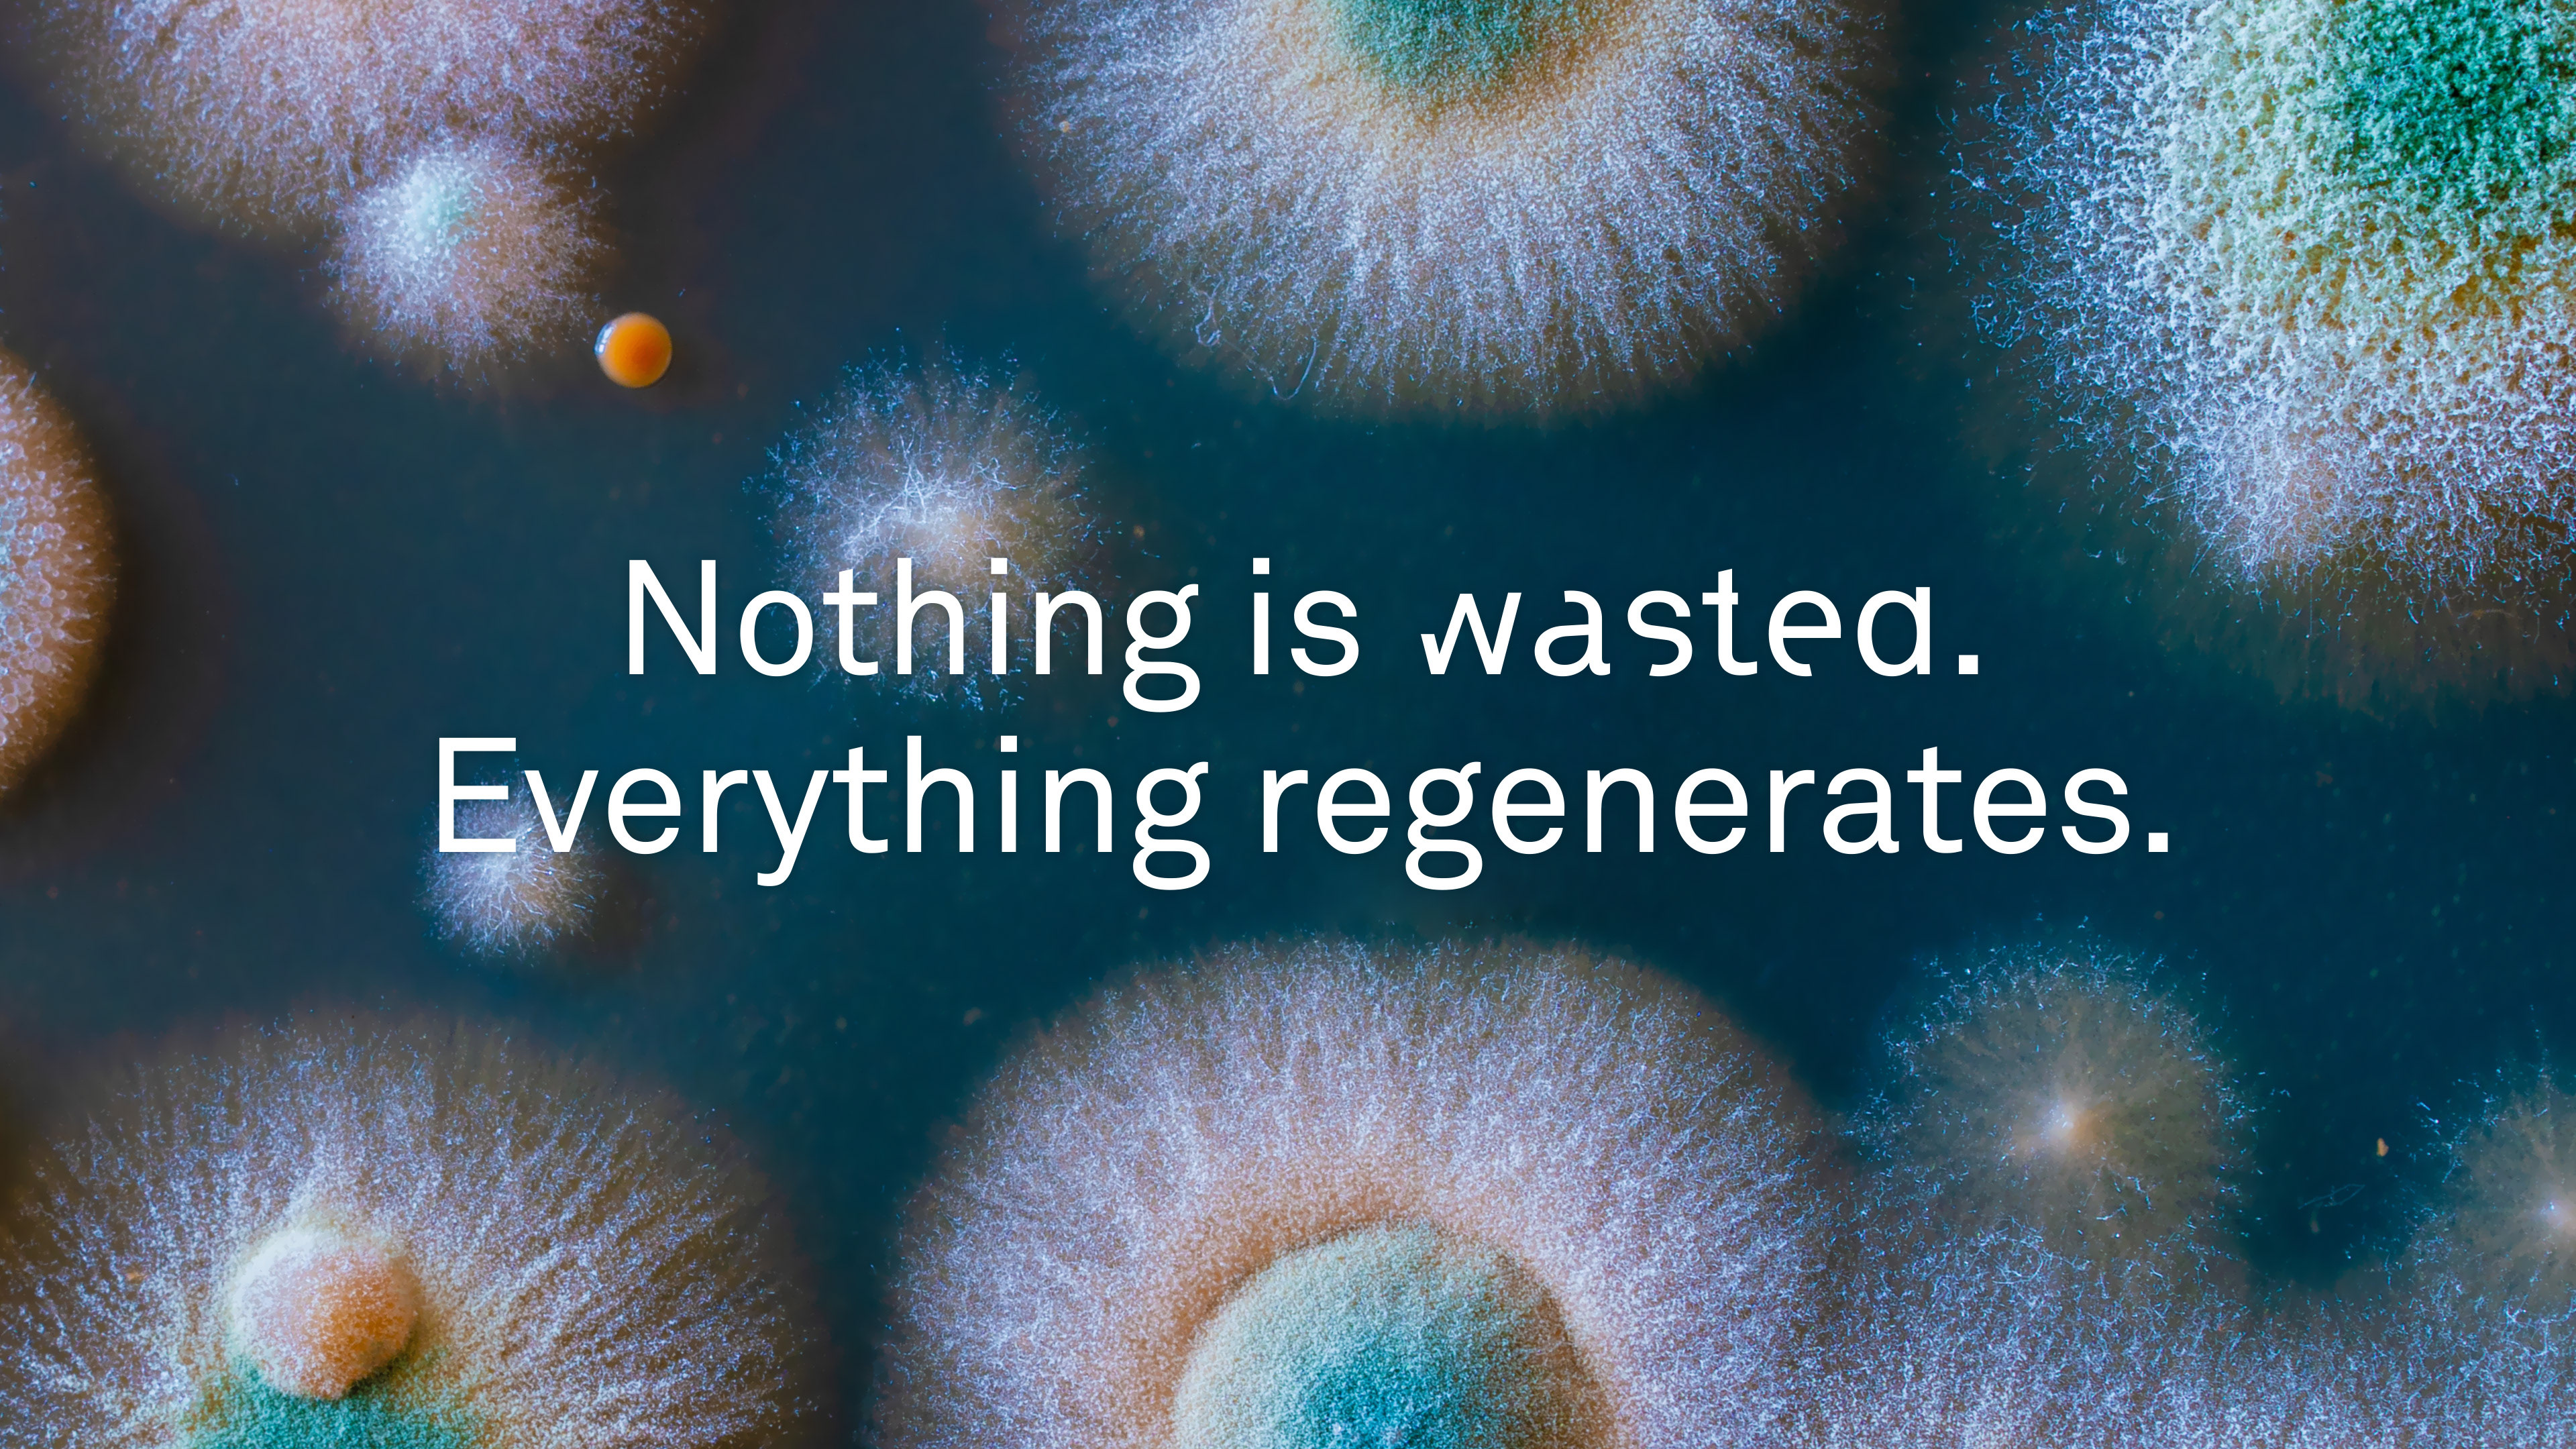

Animated Manifest
Triodos Regenerative Money Centre is a division of Triodos Bank that supports initiatives that dare to challenge and deviate from the status quo to regenerate society and the planet. It contributes to groundbreaking ideas that accelerate positive change where traditional banking and investment products cannot (yet) provide an answer.
To launch this venture into the financial world, we created a brand manifest that informs and inspires. Typography and photography are mixed with 2D and 3D animation to create a unique voice that sets TRMC apart from the traditional financial world.
Find out more
Credits
Jeroen Krielaars • Direction, Design, 2D & 3D animation
Eric Smilde • 3D modelling, texturing, lighting and rendering
Feike de Wit (SoundCircus) • Music and sound design
Norman Vladimir • Voice actor
Greo Belgers (Triodos Bank Group) • Marketing Director
Sahel Setorg (Triodos Bank Group) • Marketeer
Eric Smilde • 3D modelling, texturing, lighting and rendering
Feike de Wit (SoundCircus) • Music and sound design
Norman Vladimir • Voice actor
Greo Belgers (Triodos Bank Group) • Marketing Director
Sahel Setorg (Triodos Bank Group) • Marketeer